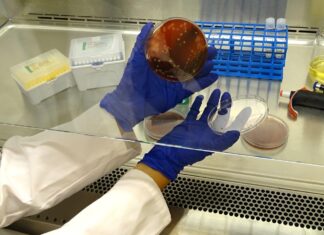
Микроскопический Воин: Как Klebsiella pneumoniae Учитсь Побеждать Антибиотики

Тайна Несокрушимой Бактериальной Защиты: Новое Открытие в Мире Клеточных Стенек
В мире микроскопических войн, где бактерии борются за выживание в условиях постоянных угроз, ученые из Университета Умео (Швеция) и Корнельского университета (США) разгадали одну...
Сон Матери: Залог Нервного Развития Ребенка
Представьте, беременность как таинственный сад, где каждый элемент, каждая мелочь влияет на распускающиеся цветы будущего ребенка. И среди этих элементов **сон матери играет...
Космическая Неравенство: Телескоп Уэбб Раскрывает Тайны Асимметрии на Экзопланете WASP-107b
В безбрежных просторах космоса, где звезды рождают свои таинственные спутники, космический телескоп Джеймса Уэбба совершил прорыв, подобный открытию нового континента. Он проливает свет...
НАСА Зовёт к Глобальному Космическому Поиску: Картирование Луны и Путь к Артемиде
В предвкушении грандиозной миссии "Артемида", которая возродит человеческий шаг на лунную поверхность спустя полвека, НАСА объявляет о захватывающем челлендже для мирового сообщества изобретателей и...
Микроскопический Воин: Как Klebsiella pneumoniae Учитсь Побеждать Антибиотики
В эпицентре непрестанной битвы за здоровье человечества разворачивается тайна, скрытая в самом сердце микроскопических воинов – бактерий. Одним из грозных противников в этой...
Раскрывая Тайны Жизни: Новые Биосенсоры Освещают Физиологические Симфонии Живых Существ
Представьте себе микроскопический мир, где клетки танцуют сложным вальсом коммуникации, а сигналы, подобно едва уловимым нотам, управляют жизненными процессами. Долгое время этот танец оставался...
Звездный термометр: Астрономы открывают тайны температурных колебаний на небе
Представьте, что вы обладаете инструментом, способным уловить едва заметные флюктуации температуры звезды, словно пульс ее внутреннего огня, с точностью до десятой доли градуса Цельсия....
Математический Лабиринт Встреч: Почему Согласование Календарей – Борьба с Экспоненциальным Хаосом
Представьте: вы пытаетесь организовать встречу не просто с коллегами, а с целой группой энтузиастов, каждый из которых живет в собственном ритме и мире обязательств....
Раскрывая Таинственный Танцпол Клетки: Энергетические Паттерны и Здоровье
Наше тело – это невероятный симфонический оркестр из миллиардов клеток, каждая из которых, подобно миниатюрному городу, кипит энергией. Эта энергия – не просто топливо...
Тайна Микроскопических Гигантов Кипра: Разгадка Древней Трагедии Мегафауны
На солнечном острове Кипр, где лазурные воды Средиземного моря сливаются с пышной зеленью, когда-то бродили удивительные существа – карликовые гиппопотамы и слоны, уменьшенные до...
Тайна Ранней Вселенной: Может ли “Антигравитация” Объяснить Ее Загадки?
Космология, наука о происхождении и эволюции Вселенной, сталкивается с двумя фундаментальными загадками, словно головоломками, которые мешают нам полностью понять ранние этапы существования нашего мира....
Языковая Эволюция: Как Связи и Идентичность Формируют Слово
Представьте себе язык как живой организм, который постоянно эволюционирует, меняется и адаптируется. Каким образом новые слова проникают в нашу речь, заменяя старые, а...
Микроскопические Вкусы, Макроскопические Последствия: Как Пищевые Предпочтения Бактерий Формируют Цикл Углерода в Океане
Глубины мирового океана – это не просто безжизненная пустота. Это динамичный мир, где микроорганизмы играют ключевую роль в глобальном климате, поглощая углекислый газ (CO2)...
Тайна Атлантики раскрыта: Найден легендарный «Лион»
В глубинах Атлантического океана, спустя почти два века после трагической гибели, наконец-то обрела покой французская пароходная мечта — «Ле Лион». Команда дайверов из США,...
Солнечный Тайна Раскрыта: Телескоп Инуйе Картирует Магнитные Поля Короны
В недрах солнечной атмосферы, в таинственной короне, где пламя достигает миллионов градусов, скрыты ключи к пониманию космической погоды и ее влияния на нашу технологически...
Сахарная Защита: Полимеры из Растений Очищают Воду от Тяжелых Металлов
Чистая вода – это не роскошь, а жизненно важная потребность. Но загрязнение вод тяжелыми металлами, такими как кадмий и свинец, представляет серьезную угрозу для...
Пустыня в ловушке: Как наводнения, усиленные опустыниванием, превращают Сахару в смертельную ловушку
Мы привыкли ассоциировать пустыню с засухой, с бесконечным песком и нехваткой воды. Но что если эта суровая картина внезапно прервется страшной стихией – наводнением?...
Крылья Гиганта: Европа Клиппер – Самый Величественный Космический Аппарат НАСА в Пути к Ледяному...
В сердце космического центра Кеннеди во Флориде разворачивается грандиозная операция, которая готовит к запуску самый масштабный планетоход в истории НАСА – Европа Клиппер. Его...
Дешифровка тайн многоцентровых катализаторов: новая модель открывает путь к совершенству
Катализаторы – это волшебные помощники в химии, ускоряющие реакции и делающие их более эффективными. Особую группу составляют многоцентровые сплавы, где активность не сосредоточена в...
Огненное Кольцо над Островом Пасхи: Невероятное Солнечное Затмение
В скором времени, 2 октября, небо над одним из самых изолированных уголков нашей планеты засияет необычным зрелищем – кольцевым солнечным затмением. Это событие подарит...